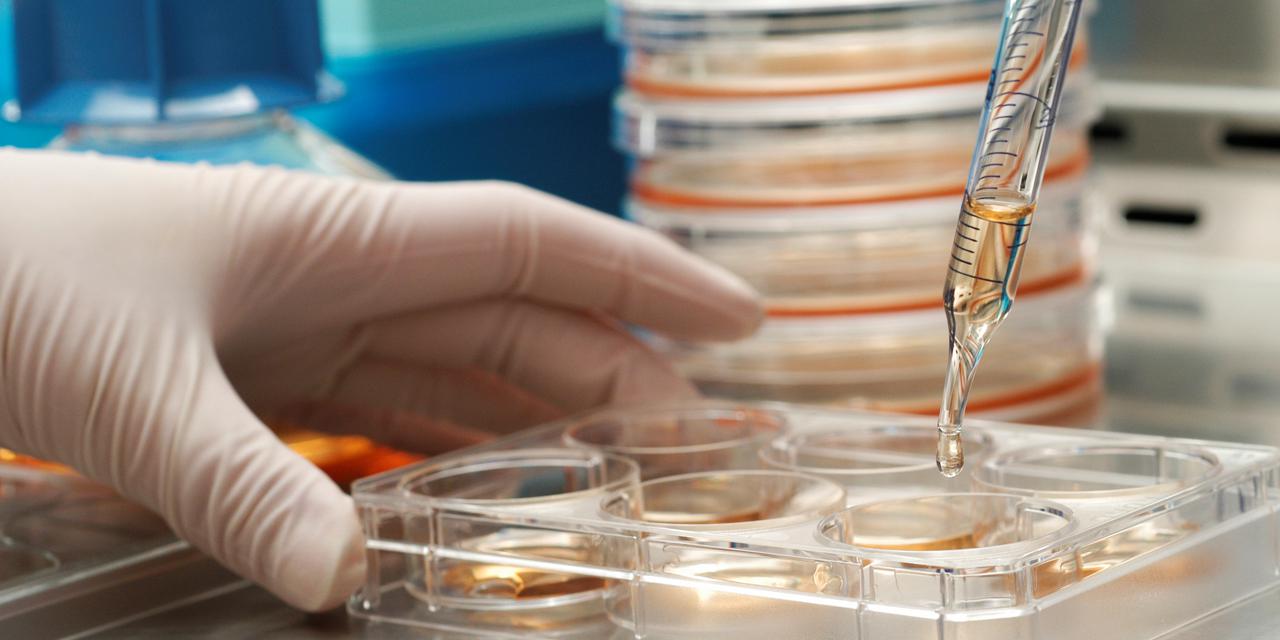

Стволовые клетки петербург
Стволовые клетки петербург 98 фотографий
Комикс мисс хид
Фильтры воздушные карманные фвк
Текст песни i say right foot creep
Котокафе букинское ш 37
Сушилка для белья потолочная 1 м
Иваньково 2
Яйцо страуса в москве
Для чего нужны стеклянные трубки
Dragons dogma 2 где найти сфинкса
Рейлинги тойота авенсис